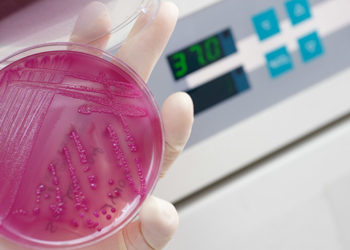

Περα απο την υγεια: οικονομικεσ επιπτωσεισ τησ αντιστασησ
Η αντοχή στα αντιβιοτικά αποτελεί ένα τρέχον πρόβλημα και μια μελλοντική πρόκληση στις μονάδες εκτροφής αιγοπροβάτων. Περιπλέκει τη θεραπεία κοινών ασθενειών όπως οι αναπνευστικές λοιμώξεις, η μαστίτιδα και η χωλότητα.
Διαβάστε περισσότερα